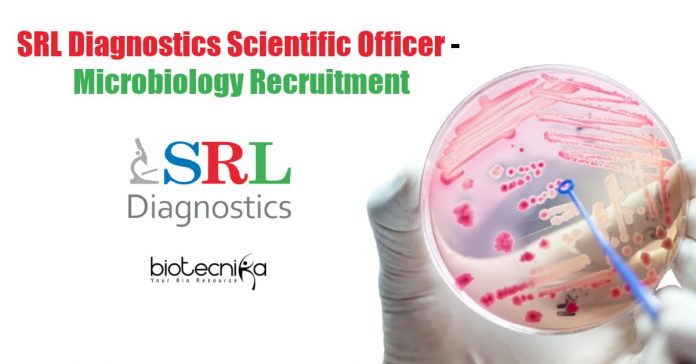

SRL Diagnostics Scientific Officer – Microbiology Recruitment
SRL Diagnostics Scientific Officer – Microbiology Recruitment. Candidates from a microbiology background are encouraged to apply for a Scientific Officer – Microbiology position at SRL Diagnostics. Interested and eligible applicants can check out all of the details on the same below:
Designation: Scientific Officer – Microbiology
Location: Mumbai
Experience: 1 to 2 year(s) of Experience
Industry: Medical / Healthcare / Hospitals
Functional Area: Other
Role Category: Other
Salary: Not Disclosed by Recruiter
Job Description:
- Performing test within TAT as per defined Standard Operating Procedure (SOP).
- To analyze the internal and external quality assurance specimen/ samples.
- Performing calibrations and also running of controls according to SOP.
- To incorporate result entry of tests performed.
- To ensure everyday instrument maintenance.
- To maintain records of all reports.
- Maintain proper storage of specimens/ samples according to SOP.
- Observing lab safety precautions in handling clinical specimens as well as running of tests.
- Critical/abnormal findings to be escalated.
Education:
- UG:
- PG: MS/M.Sc(Science) in Microbiology
- Doctorate: Doctorate Not Required
Apply Online
Editor’s Note: SRL Diagnostics Bioinformatics Scientist Recruitment – Apply Online. Please make sure that you are subscribed to the Biotecnika Times Newsletter and our YouTube channel to be notified of all of the latest in the industry. Follow us on all of our social media like Twitter, Telegram, Facebook and Instagram.

I need this job I have 10 months experience in testing of RT PCR test handled covid samples, experience in molecular biology section
Kindly send me mail id. To share my resume.
Dear Jyoti,
Please click on Apply Online given on the page to apply for this post.
Kindly send me a mail I’d or website to share my resume.
Dear Shaista,
Please click on Apply Online given on the page to apply for this post.
Yess I’m interested .pleace share your mail I’d soo I can send my c.v ..